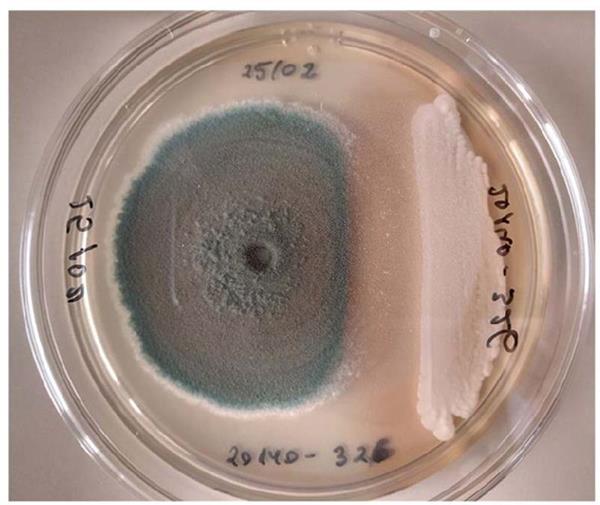
Metschnikowia pulcherrima

Tecnología de los alimentos
- Diseño de procesos y caracterización de productos derivados de la manzana
- Desarrollo de nuevos productos derivados de la manzana
- Caracterización de microorganismos autóctonos para fermentación de sidra
- Selección clonal para la obtención de material vitícola certificado
- Aprovechamiento de subproductos de la producción sidrera (magaya, borras)
- Identificación de compuestos bioactivos en subproductos agroalimentarios